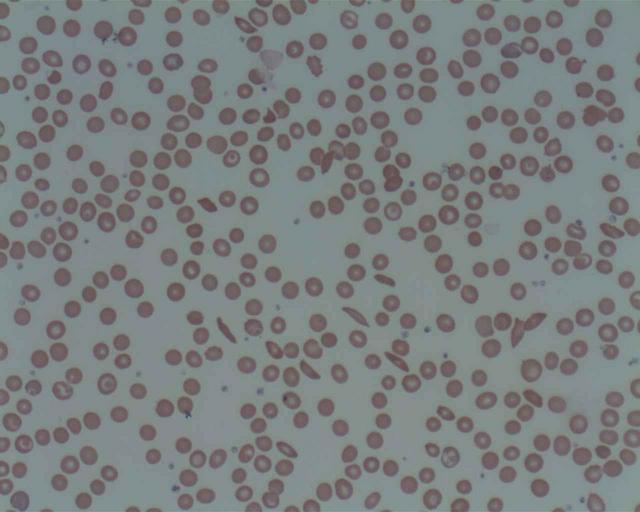

MAKE A MEME
View Large Image
| View Original: | Sickle Cell Disease.jpg (1280x1024) | |||
| Download: | Original | Medium | Small | Thumb |
| Courtesy of: | commons.wikimedia.org | More Like This | ||
| Keywords: Sickle Cell Disease.jpg en Sickle Cell Drepanocytes are found in patient with sickle cell anaemia and other sickle syndromes but not in sickle trait They are banana shaped red cells They are commonly seen in patients with sickle cell anaemia- a hereditary blood disorder characterized by an abnormality in the oxygen-carrying haemoglobin molecule in the cytoplasm of the red cells resulting in the formation of abnormal rigid sickle shape red cells 2014-11-15 Prof Osaro Erhabor Prof Osaro Erhabor other versions cc-zero Uploaded with UploadWizard Sickle-cell anemia | ||||